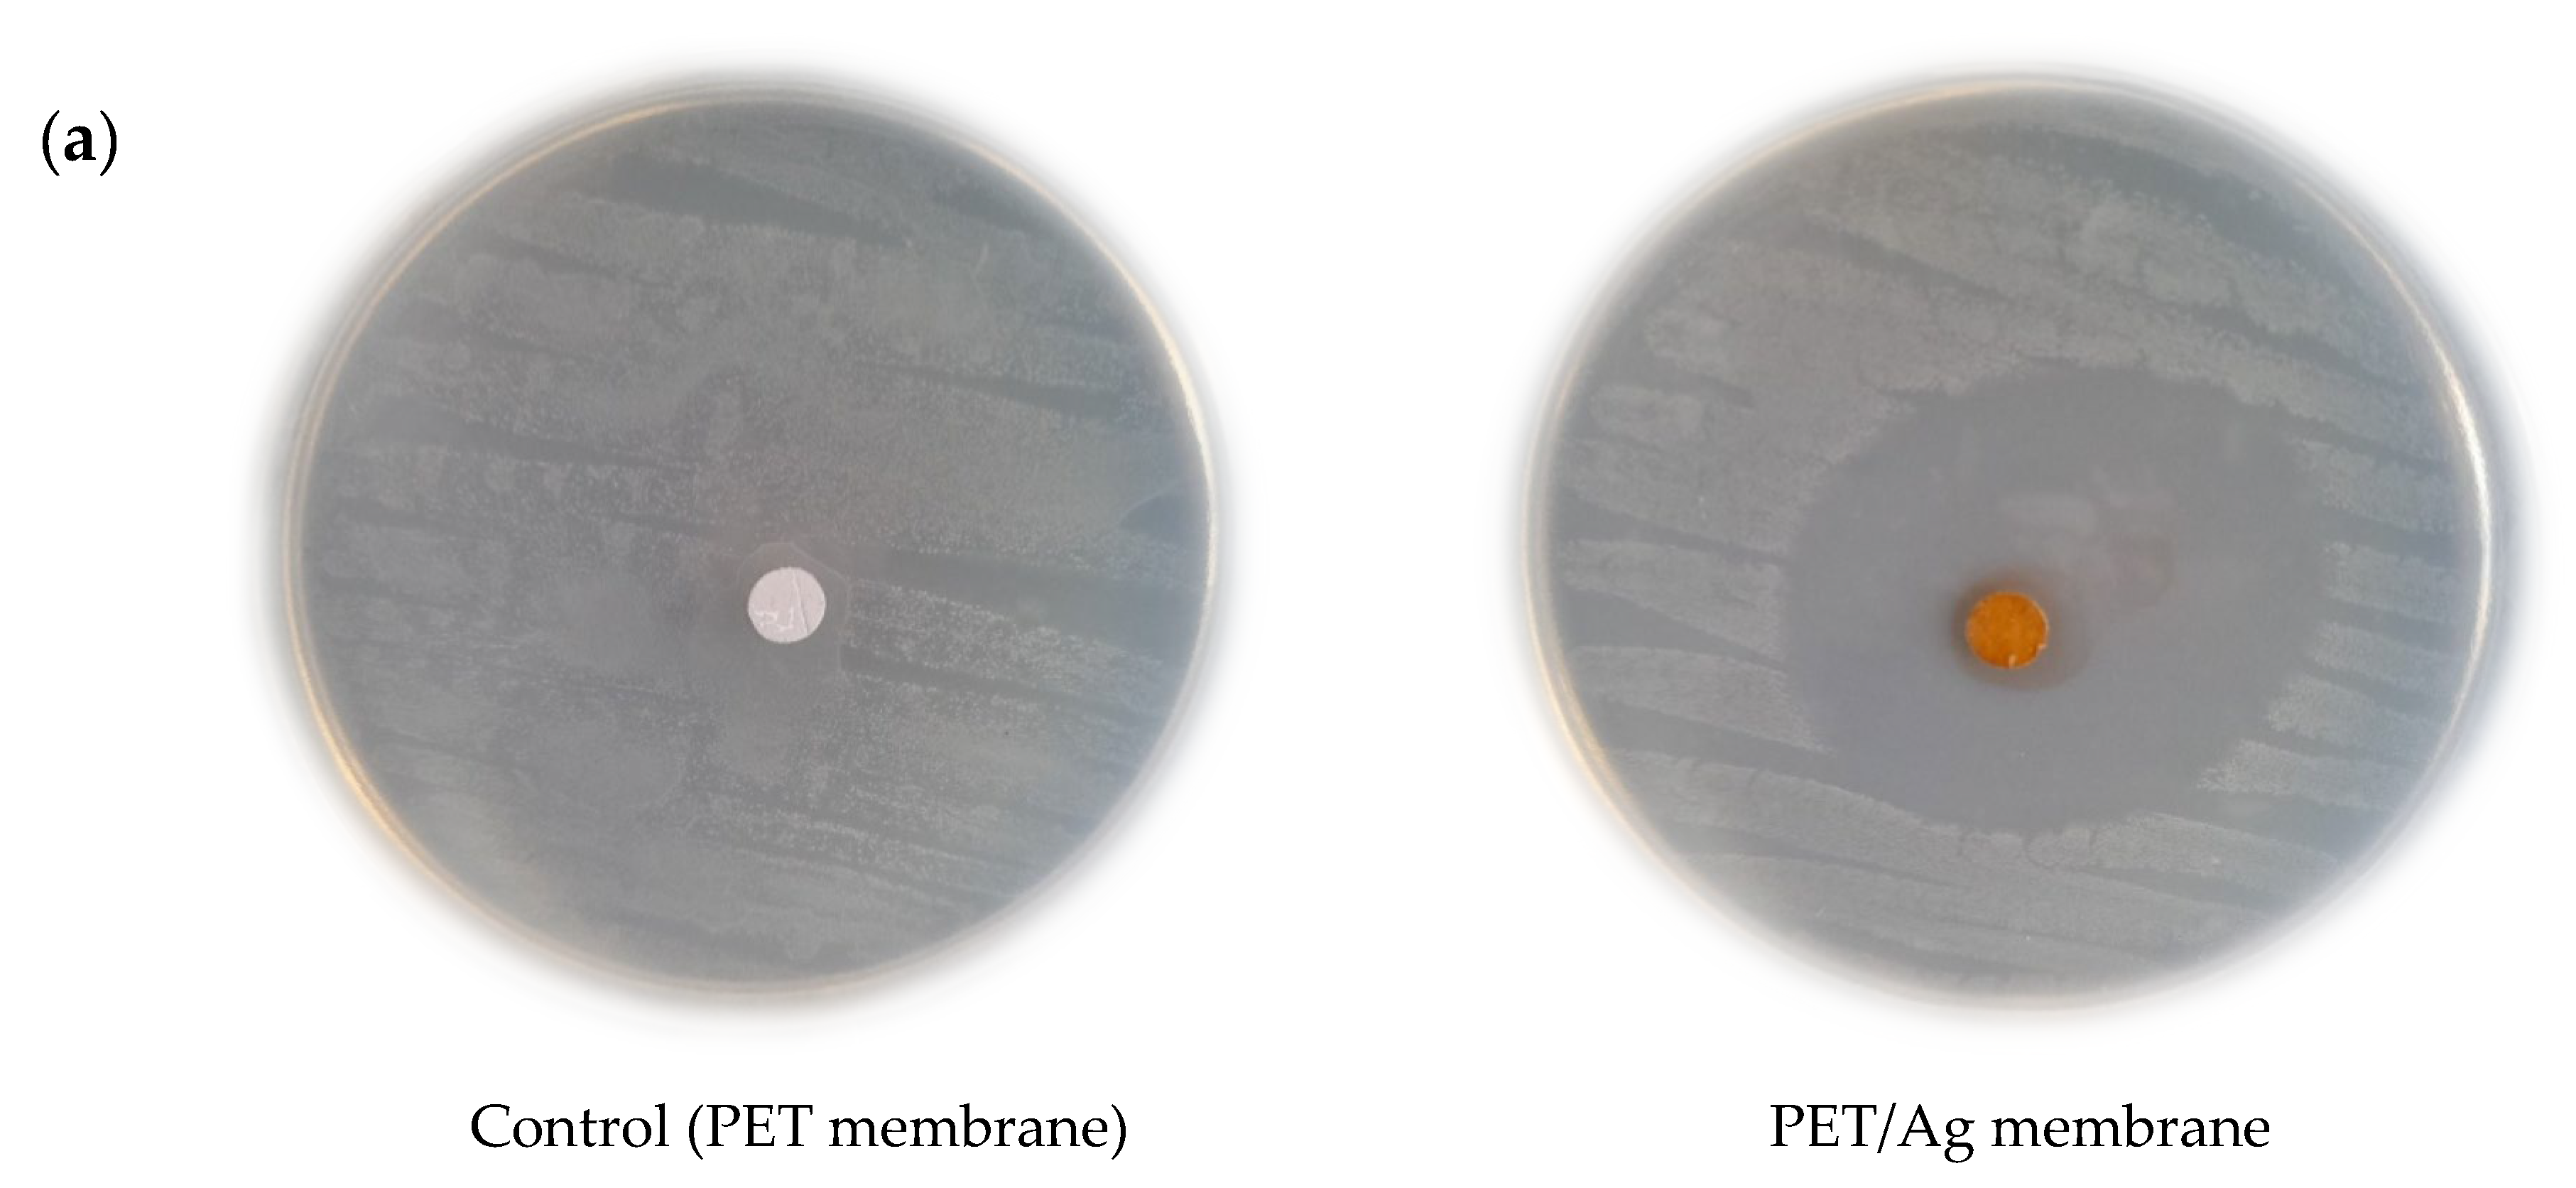
Molecules 28 05439 g005a

Antimicrobial Activities of Polyethylene Terephthalate-Waste-Derived Nanofibrous Membranes Decorated with Green Synthesized Ag Nanoparticles
Abstract
:1. Introduction
2. Results and Discussion
2.1. Characterization
2.2. Antimicrobial Activity
3. Experimental Section
3.1. Materials
3.2. Fabrication of Electrospun PET Membrane
3.3. Modification of Electrospun PET Membrane
3.4. Preparation of the Curcumin Powder Extract
3.5. Green Synthesis of Ag Nanoparticles onto Electrospun PET Nanofiber Surface
3.6. Antibacterial Studies
3.7. Effect of Nanofibrous Membranes on the Planktonic Cultures
3.8. Investigation of Biofilm Formation
3.9. Characterization
4. Conclusions
Author Contributions
Funding
Institutional Review Board Statement
Informed Consent Statement
Data Availability Statement
Acknowledgments
Conflicts of Interest
References
- Topuz, F.; Oldal, D.G.; Szekely, G. Valorization of Polyethylene Terephthalate (PET) Plastic Wastes as Nanofibrous Membranes for Oil Removal: Sustainable Solution for Plastic Waste and Oil Pollution. Ind. Eng. Chem. Res. 2022, 61, 9077–9086. [Google Scholar] [CrossRef]
- Ryberg, M.W.; Hauschild, M.Z.; Wang, F.; Averous-Monnery, S.; Laurent, A. Global environmental losses of plastics across their value chains. Resour. Conserv. Recycl. 2019, 151, 104459. [Google Scholar] [CrossRef]
- Xiong, Q.; Tian, Q.; Yue, X.; Xu, J.; He, X.; Qiu, F.; Zhang, T. Superhydrophobic PET@ ZnO Nanofibrous Membrane Extract from Waste Plastic for Efficient Water-In-Oil Emulsion Separation. Ind. Eng. Chem. Res. 2022, 61, 11804–11814. [Google Scholar] [CrossRef]
- Hossain, M.T.; Shahid, M.A.; Ali, A. Development of nanofibrous membrane from recycled polyethene terephthalate bottle by electrospinning. OpenNano 2022, 8, 100089. [Google Scholar] [CrossRef]
- Djapovic, M.; Milivojevic, D.; Ilic-Tomic, T.; Lješević, M.; Nikolaivits, E.; Topakas, E.; Maslak, V.; Nikodinovic-Runic, J. Synthesis and characterization of polyethylene terephthalate (PET) precursors and potential degradation products: Toxicity study and application in discovery of novel PETases. Chemosphere 2021, 275, 130005. [Google Scholar] [CrossRef]
- Yasin, S.; Bakr, Z.H.; Ali, G.A.; Saeed, I. Recycling nanofibers from polyethylene terephthalate waste using electrospinning technique. Waste Recycl. Technol. Nanomater. Manuf. 2021, 805–821. [Google Scholar] [CrossRef]
- Suhaimi, N.A.S.; Muhamad, F.; Abd Razak, N.A.; Zeimaran, E. Recycling of polyethylene terephthalate wastes: A review of technologies, routes, and applications. Polym. Eng. Sci. 2022, 62, 2355–2375. [Google Scholar] [CrossRef]
- Zhong, S.; Gurnis, M. Dynamic interaction between tectonic plates, subducting slabs, and the mantle. Earth Interact. 1997, 1, 1–18. [Google Scholar] [CrossRef]
- Wu, S.; Dong, T.; Li, Y.; Sun, M.; Qi, Y.; Liu, J.; Kuss, M.A.; Chen, S.; Duan, B. State-of-the-art review of advanced electrospun nanofiber yarn-based textiles for biomedical applications. Appl. Mater. Today 2022, 27, 101473. [Google Scholar] [CrossRef]
- Sorkhabi, T.S.; Samberan, M.F.; Ostrowski, K.A.; Zajdel, P.; Stempkowska, A.; Gawenda, T. Electrospinning of Poly (Acrylamide), Poly (Acrylic Acid) and Poly (Vinyl Alcohol) Nanofibers: Characterization and Optimization Study on the Effect of Different Parameters on Mean Diameter Using Taguchi Design of Experiment Method. Materials 2022, 15, 5876. [Google Scholar] [CrossRef]
- Hiremath, L.; Sruti, O.; Aishwarya, B.; Kala, N.; Keshamma, E. Electrospun nanofibers: Characteristic agents and their applications. In Nanofibers-Synthesis, Properties and Applications; IntechOpen: London, UK, 2021. [Google Scholar] [CrossRef]
- Gao, Y.; Bach Truong, Y.; Zhu, Y.; Louis Kyratzis, I. Electrospun antibacterial nanofibers: Production, activity, and in vivo applications. J. Appl. Polym. Sci. 2014, 131, 40797. [Google Scholar] [CrossRef]
- Wang, C.; Wang, J.; Zeng, L.; Qiao, Z.; Liu, X.; Liu, H.; Zhang, J.; Ding, J. Fabrication of electrospun polymer nanofibers with diverse morphologies. Molecules 2019, 24, 834. [Google Scholar] [CrossRef] [PubMed] [Green Version]
- Sorkhabi, T.S.; Samberan, M.F.; Ostrowski, K.A.; Majka, T.M. Novel synthesis, characterization and amoxicillin release study of pH-sensitive Nanosilica/poly (acrylic acid) macroporous hydrogel with high swelling. Materials 2022, 15, 469. [Google Scholar] [CrossRef]
- Sorkhabi, T.S.; Samberan, M.F.; Ostrowski, K.A.; Majka, T.M.; Piechaczek, M.; Zajdel, P. Preparation and Characterization of Novel Microgels Containing Nano-SiO2 and Copolymeric Hydrogel Based on Poly (Acrylamide) and Poly (Acrylic Acid): Morphological, Structural and Swelling Studies. Materials 2022, 15, 4782. [Google Scholar] [CrossRef]
- Cheng, Y.; Xiong, Y.; Pan, M.; Li, L.; Dong, L. A flexible, sensitive and stable humidity sensor based on an all-polymer nanofiber film. Mater. Lett. 2023, 330, 133268. [Google Scholar] [CrossRef]
- Ghorani, B.; Emadzadeh, B.; Fooladi, E.; Tucker, N. Designing a colorimetric nanosensor based on dithizone and cholesteric liquid crystals loaded in electrospun cellulose acetate nanofibers: Monitoring the quality of pistachio as a case study. J. Appl. Polym. Sci. 2023, 140, e53472. [Google Scholar] [CrossRef]
- Ghosal, K.; Augustine, R.; Zaszczynska, A.; Barman, M.; Jain, A.; Hasan, A.; Kalarikkal, N.; Sajkiewicz, P.; Thomas, S. Novel drug delivery systems based on triaxial electrospinning based nanofibers. React. Funct. Polym. 2021, 163, 104895. [Google Scholar] [CrossRef]
- Atila, D.; Keskin, D.; Lee, Y.-L.; Lin, F.-H.; Hasirci, V.; Tezcaner, A. Injectable methacrylated gelatin/thiolated pectin hydrogels carrying melatonin/tideglusib-loaded core/shell PMMA/silk fibroin electrospun fibers for vital pulp regeneration. Colloids Surf. B Biointerfaces 2023, 222, 113078. [Google Scholar] [CrossRef] [PubMed]
- Abdul Hameed, M.M.; Mohamed Khan, S.A.P.; Thamer, B.M.; Rajkumar, N.; El-Hamshary, H.; El-Newehy, M. Electrospun nanofibers for drug delivery applications: Methods and mechanism. Polym. Adv. Technol. 2023, 34, 6–23. [Google Scholar] [CrossRef]
- Villarreal-Gómez, L.J.; Pérez-González, G.L. Electrospinning for Drug Delivery Applications. In Nano-and Microfabrication Techniques in Drug Delivery: Recent Developments and Future Prospects; Springer: Berlin/Heidelberg, Germany, 2023; pp. 21–40. [Google Scholar] [CrossRef]
- Brimo, N.; Serdaroğlu, D.Ç.; Uyar, T.; Uysal, B.; Çakıcı, E.B.; Dikmen, M.; Canturk, Z. Novel electrospun polymeric nanofibers loaded different medicaments as drug delivery systems for regenerative endodontics. Curr. Drug Deliv. 2023, 20, 992–1014. [Google Scholar] [CrossRef]
- Fang, Y.; Zhu, X.; Wang, N.; Zhang, X.; Yang, D.; Nie, J.; Ma, G. Biodegradable core-shell electrospun nanofibers based on PLA and γ-PGA for wound healing. Eur. Polym. J. 2019, 116, 30–37. [Google Scholar] [CrossRef]
- Uhljar, L.É.; Ambrus, R. Electrospinning of Potential Medical Devices (Wound Dressings, Tissue Engineering Scaffolds, Face Masks) and Their Regulatory Approach. Pharmaceutics 2023, 15, 417. [Google Scholar] [CrossRef] [PubMed]
- Yusuf Aliyu, A.; Adeleke, O.A. Nanofibrous Scaffolds for Diabetic Wound Healing. Pharmaceutics 2023, 15, 986. [Google Scholar] [CrossRef]
- Ye, K.; Kuang, H.; You, Z.; Morsi, Y.; Mo, X. Electrospun nanofibers for tissue engineering with drug loading and release. Pharmaceutics 2019, 11, 182. [Google Scholar] [CrossRef] [Green Version]
- Atila, D.; Hasirci, V.; Tezcaner, A. Coaxial electrospinning of composite mats comprised of core/shell poly (methyl methacrylate)/silk fibroin fibers for tissue engineering applications. J. Mech. Behav. Biomed. Mater. 2022, 128, 105105. [Google Scholar] [CrossRef]
- Erdoğmuş, S.F.; Altıntaş, Ö.E.; Çelik, S. Production of fungal chitosan and fabrication of fungal chitosan/polycaprolactone electrospun nanofibers for tissue engineering. Microsc. Res. Tech. 2023, 1–13. [Google Scholar] [CrossRef]
- Banitaba, S.N.; Ebadi, S.V.; Salimi, P.; Bagheri, A.; Gupta, A.; Arifeen, W.U.; Chaudhary, V.; Mishra, Y.K.; Kaushik, A.; Mostafavi, E. Biopolymer-based electrospun fibers in electrochemical devices: Versatile platform for energy, environment, and health monitoring. Mater. Horiz. 2022, 9, 2914–2948. [Google Scholar] [CrossRef] [PubMed]
- Šišková, A.O.; Frajová, J.; Nosko, M. Recycling of poly (ethylene terephthalate) by electrospinning to enhanced the filtration efficiency. Mater. Lett. 2020, 278, 128426. [Google Scholar] [CrossRef]
- Kamrani, H.; Nosrati, A. Fabrication of nanofiber filtration membranes using polyethylene terephthalate (PET): A review. J. Membr. Sci. Technol. 2018, 8, 1000183. [Google Scholar] [CrossRef]
- Fu, J.; Hu, N.; Yang, Z.; Wang, L. Experimental study on zero liquid discharge (ZLD) of FGD wastewater from a coal-fired power plant by flue gas exhausted heat. J. Water Process. Eng. 2018, 26, 100–107. [Google Scholar] [CrossRef]
- Aijaz, M.O.; Karim, M.R.; Othman, M.H.D.; Samad, U.A. Anti-fouling/wetting electrospun nanofibrous membranes for membrane distillation desalination: A comprehensive review. Desalination 2023, 553, 116475. [Google Scholar] [CrossRef]
- Asgari, S.; Ziarani, G.M.; Badiei, A.; Ajalloueian, F.; Vasseghian, Y. Electrospun composite nanofibers as novel high-performance and visible-light photocatalysts for removal of environmental pollutants: A review. Environ. Res. 2022, 215, 114296. [Google Scholar] [CrossRef] [PubMed]
- Yahaya, N.; Ishak, S.M.; Mohamed, A.H.; Kamaruzaman, S.; Zain, N.N.M.; Waras, M.N.; Hassan, Y.; Abd Aziz, N.; Miskam, M.; Abdullah, W.N.W. Recent applications of electrospun nanofibres in microextraction based-sample preparation techniques for determination of environmental pollutants. Curr. Opin. Environ. Sci. Health 2022, 26, 100323. [Google Scholar] [CrossRef]
- Song, K.; Wu, Q.; Qi, Y.; Kärki, T. Electrospun nanofibers with antimicrobial properties. Electrospun Nanofibers 2017, 551–569. [Google Scholar] [CrossRef]
- Ditaranto, N.; Basoli, F.; Trombetta, M.; Cioffi, N.; Rainer, A. Electrospun nanomaterials implementing antibacterial inorganic nanophases. Appl. Sci. 2018, 8, 1643. [Google Scholar] [CrossRef] [Green Version]
- Guo, L.; Yuan, W.; Lu, Z.; Li, C.M. Polymer/nanosilver composite coatings for antibacterial applications. Colloids Surf. A Physicochem. Eng. Asp. 2013, 439, 69–83. [Google Scholar] [CrossRef]
- Alsammarraie, F.K.; Wang, W.; Zhou, P.; Mustapha, A.; Lin, M. Green synthesis of silver nanoparticles using turmeric extracts and investigation of their antibacterial activities. Colloids Surf. B Biointerfaces 2018, 171, 398–405. [Google Scholar] [CrossRef] [PubMed]
- Rodríguez-Félix, F.; Graciano-Verdugo, A.Z.; Moreno-Vásquez, M.J.; Lagarda-Díaz, I.; Barreras-Urbina, C.G.; Armenta-Villegas, L.; Olguín-Moreno, A.; Tapia-Hernández, J.A. Trends in sustainable green synthesis of silver nanoparticles using agri-food waste extracts and their applications in health. J. Nanomater. 2022, 2022, 8874003. [Google Scholar] [CrossRef]
- Villarreal-Gómez, L.J.; Pérez-González, G.L.; Bogdanchikova, N.; Pestryakov, A.; Nimaev, V.; Soloveva, A.; Cornejo-Bravo, J.M.; Toledaño-Magaña, Y. Antimicrobial effect of electrospun nanofibers loaded with silver nanoparticles: Influence of Ag incorporation method. J. Nanomater. 2021, 2021, 9920755. [Google Scholar] [CrossRef]
- Allizond, V.; Banche, G.; Salvoni, M.; Malandrino, M.; Cecone, C.; Cuffini, A.M.; Bracco, P. Facile One-Step Electrospinning Process to Prepare AgNPs-Loaded PLA and PLA/PEO Mats with Antibacterial Activity. Polymers 2023, 15, 1470. [Google Scholar] [CrossRef]
- Sarviya, N.; Mahanta, U.; Dart, A.; Giri, J.; Deshpande, A.S.; Khandelwal, M.; Bhave, M.; Kingshott, P. Biocompatible and antimicrobial multilayer fibrous polymeric wound dressing with optimally embedded silver nanoparticles. Appl. Surf. Sci. 2023, 612, 155799. [Google Scholar] [CrossRef]
- Abdoltajedini, F.; Hadjizadeh, A.; Ajji, A. Fabrication and characterization of polymeric nano/micro fibers containing silver nanoparticles for biomedical applications. Int. J. Polym. Mater. Polym. Biomater. 2023, 72, 144–161. [Google Scholar] [CrossRef]
- Rybka, M.; Mazurek, Ł.; Konop, M. Beneficial Effect of Wound Dressings Containing Silver and Silver Nanoparticles in Wound Healing—From Experimental Studies to Clinical Practice. Life 2023, 13, 69. [Google Scholar] [CrossRef] [PubMed]
- Ghosh, A.; De, S.K.; Mondal, S.; Halder, A.; Barai, M.; Guchhait, K.C.; Raul, P.; Karmakar, S.; Ghosh, C.; Patra, A. Green synthesis of silver nanoparticles and its applications as sensor, catalyst, and antibacterial agent. Mater. Today Proc. 2023, 1–8. [Google Scholar] [CrossRef]
- Alavi, M.; Hamblin, M.R. Antibacterial silver nanoparticles: Effects on bacterial nucleic acids. Cell. Mol. Biomed. Rep. 2023, 3, 35–40. [Google Scholar] [CrossRef]
- San Keskin, N.O.; Deniz, F.; Nazır, H. Anti microbial corrosion properties of electrospun cellulose acetate nanofibers containing biogenic silver nanoparticles for copper coatings. RSC Adv. 2020, 10, 39901–39908. [Google Scholar] [CrossRef]
- Kaur, A.; Preet, S.; Kumar, V.; Kumar, R.; Kumar, R. Synergetic effect of vancomycin loaded silver nanoparticles for enhanced antibacterial activity. Colloids Surf. B Biointerfaces 2019, 176, 62–69. [Google Scholar] [CrossRef]
- Smirnov, O.; Kalynovskyi, V.; Zelena, P.; Yumyna, Y.; Dzhagan, V.; Kovalenko, M.; Konotop, Y.; Taran, N. Bactericidal activity of Ag nanoparticles biosynthesized from Capsicum annuum pericarps against phytopathogenic Clavibacter michiganensis. Sci. Nat. 2023, 110, 15. [Google Scholar] [CrossRef]
- Tran, Q.H.; Le, A.-T. Silver nanoparticles: Synthesis, properties, toxicology, applications and perspectives. Adv. Nat. Sci. Nanosci. Nanotechnol. 2013, 4, 033001. [Google Scholar] [CrossRef] [Green Version]
- Mbagwu, F.; Auta, S.; Bankole, M.; Kovo, A.; Abioye, O. Biosynthesis and characterization of silver nanoparticles using Bacillus subtilis, Escherichia coli, and leaf extracts of Jatropha and Ocimum species. Int. Nano Lett. 2023, 13, 63–73. [Google Scholar] [CrossRef]
- Kowsalya, E.; MosaChristas, K.; Balashanmugam, P.; Rani, J.C. Biocompatible silver nanoparticles/poly (vinyl alcohol) electrospun nanofibers for potential antimicrobial food packaging applications. Food Packag. Shelf Life 2019, 21, 100379. [Google Scholar] [CrossRef]
- Kundu, S.; Nithiyanantham, U. In situ formation of curcumin stabilized shape-selective Ag nanostructures in aqueous solution and their pronounced SERS activity. Rsc Adv. 2013, 3, 25278–25290. [Google Scholar] [CrossRef]
- Nelson, K.M.; Dahlin, J.L.; Bisson, J.; Graham, J.; Pauli, G.F.; Walters, M.A. The essential medicinal chemistry of curcumin: Miniperspective. J. Med. Chem. 2017, 60, 1620–1637. [Google Scholar] [CrossRef] [PubMed]
- Priyadarsini, K.I. The chemistry of curcumin: From extraction to therapeutic agent. Molecules 2014, 19, 20091–20112. [Google Scholar] [CrossRef] [PubMed] [Green Version]
- Selvan, D.A.; Mahendiran, D.; Kumar, R.S.; Rahiman, A.K. Garlic, green tea and turmeric extracts-mediated green synthesis of silver nanoparticles: Phytochemical, antioxidant and in vitro cytotoxicity studies. J. Photochem. Photobiol. B Biol. 2018, 180, 243–252. [Google Scholar] [CrossRef]
- Al-Namil, D.S.; Khoury, E.E.; Patra, D. Solid-state green synthesis of Ag NPs: Higher temperature harvests larger Ag NPs but smaller size has better catalytic reduction reaction. Sci. Rep. 2019, 9, 15212. [Google Scholar] [CrossRef] [Green Version]
- Al-Namil, D.S.; Patra, D. Green solid-state based curcumin mediated rhamnolipids stabilized silver nanoparticles: Interaction of silver nanoparticles with cystine and albumins towards fluorescence sensing. Colloids Surf. B Biointerfaces 2019, 173, 647–653. [Google Scholar] [CrossRef]
- Baruah, K.; Konthoujam, I.; Lyndem, S.; Aguan, K.; Roy, A.S. Complexation of turmeric and curcumin mediated silver nanoparticles with human serum albumin: Further investigation into the protein-corona formation, anti-bacterial effects and cell cytotoxicity studies. Spectrochim. Acta Part A Mol. Biomol. Spectrosc. 2023, 294, 122540. [Google Scholar] [CrossRef]
- Verma, A.; Jain, N.; Singha, S.; Quraishi, M.; Sinha, I. Green synthesis and catalytic application of curcumin stabilized silver nanoparticles. J. Chem. Sci. 2016, 128, 1871–1878. [Google Scholar] [CrossRef]
- Tavanai, H. A new look at the modification of polyethylene terephthalate by sodium hydroxide. J. Text. Inst. 2009, 100, 633–639. [Google Scholar] [CrossRef]
- Sichani, G.N.; Morshed, M.; Amirnasr, M.; Abedi, D. In situ preparation, electrospinning, and characterization of polyacrylonitrile nanofibers containing silver nanoparticles. J. Appl. Polym. Sci. 2010, 116, 1021–1029. [Google Scholar] [CrossRef]
- Wang, Y.; Yang, Q.; Shan, G.; Wang, C.; Du, J.; Wang, S.; Li, Y.; Chen, X.; Jing, X.; Wei, Y. Preparation of silver nanoparticles dispersed in polyacrylonitrile nanofiber film spun by electrospinning. Mater. Lett. 2005, 59, 3046–3049. [Google Scholar] [CrossRef]
- Sanchez-Cortes, S.; Garcıa-Ramos, J.; Morcillo, G.; Tinti, A. Morphological study of silver colloids employed in surface-enhanced Raman spectroscopy: Activation when exciting in visible and near-infrared regions. J. Colloid Interface Sci. 1995, 175, 358–368. [Google Scholar] [CrossRef]
- Chinchillas-Chinchillas, M.J.; Orozco-Carmona, V.M.; Alvarado-Beltrán, C.G.; Almaral-Sánchez, J.L.; Sepulveda-Guzman, S.; Jasso-Ramos, L.E.; Castro-Beltrán, A. Synthesis of recycled poly (ethylene terephthalate)/polyacrylonitrile/styrene composite nanofibers by electrospinning and their mechanical properties evaluation. J. Polym. Environ. 2019, 27, 659–669. [Google Scholar] [CrossRef]
- Jamdar, V.; Kathalewar, M.; Dubey, K.A.; Sabnis, A. Recycling of PET wastes using Electron beam radiations and preparation of polyurethane coatings using recycled material. Prog. Org. Coat. 2017, 107, 54–63. [Google Scholar] [CrossRef]
- Svinterikos, E.; Zuburtikudis, I. Carbon nanofibers from renewable bioresources (lignin) and a recycled commodity polymer [poly (ethylene terephthalate)]. J. Appl. Polym. Sci. 2016, 133, 1097–4628. [Google Scholar] [CrossRef]
- Djebara, M.; Stoquert, J.; Abdesselam, M.; Muller, D.; Chami, A. FTIR analysis of polyethylene terephthalate irradiated by MeV He+. Nucl. Instrum. Methods Phys. Res. Sect. B Beam Interact. Mater. At. 2012, 274, 70–77. [Google Scholar] [CrossRef]
- Nadagouda, M.N.; Iyanna, N.; Lalley, J.; Han, C.; Dionysiou, D.D.; Varma, R.S. Synthesis of silver and gold nanoparticles using antioxidants from blackberry, blueberry, pomegranate, and turmeric extracts. ACS Sustain. Chem. Eng. 2014, 2, 1717–1723. [Google Scholar] [CrossRef]

| Element | Weight% | Atomic% |
|---|---|---|
| C | 64.15 | 70.44 |
| O | 35.85 | 29.56 |
| Element | Weight% | Atomic% |
|---|---|---|
| C | 59.74 | 67.28 |
| O | 38.42 | 32.49 |
| Ag | 1.84 | 0.23 |
Disclaimer/Publisher’s Note: The statements, opinions and data contained in all publications are solely those of the individual author(s) and contributor(s) and not of MDPI and/or the editor(s). MDPI and/or the editor(s) disclaim responsibility for any injury to people or property resulting from any ideas, methods, instructions or products referred to in the content. |
© 2023 by the authors. Licensee MDPI, Basel, Switzerland. This article is an open access article distributed under the terms and conditions of the Creative Commons Attribution (CC BY) license (https://creativecommons.org/licenses/by/4.0/).
Share and Cite
Soltanolzakerin-Sorkhabi, T.; Fallahi-Samberan, M.; Kumaravel, V. Antimicrobial Activities of Polyethylene Terephthalate-Waste-Derived Nanofibrous Membranes Decorated with Green Synthesized Ag Nanoparticles. Molecules 2023, 28, 5439. https://doi.org/10.3390/molecules28145439
Soltanolzakerin-Sorkhabi T, Fallahi-Samberan M, Kumaravel V. Antimicrobial Activities of Polyethylene Terephthalate-Waste-Derived Nanofibrous Membranes Decorated with Green Synthesized Ag Nanoparticles. Molecules. 2023; 28(14):5439. https://doi.org/10.3390/molecules28145439
Chicago/Turabian StyleSoltanolzakerin-Sorkhabi, Tannaz, Mehrab Fallahi-Samberan, and Vignesh Kumaravel. 2023. "Antimicrobial Activities of Polyethylene Terephthalate-Waste-Derived Nanofibrous Membranes Decorated with Green Synthesized Ag Nanoparticles" Molecules 28, no. 14: 5439. https://doi.org/10.3390/molecules28145439
APA StyleSoltanolzakerin-Sorkhabi, T., Fallahi-Samberan, M., & Kumaravel, V. (2023). Antimicrobial Activities of Polyethylene Terephthalate-Waste-Derived Nanofibrous Membranes Decorated with Green Synthesized Ag Nanoparticles. Molecules, 28(14), 5439. https://doi.org/10.3390/molecules28145439









